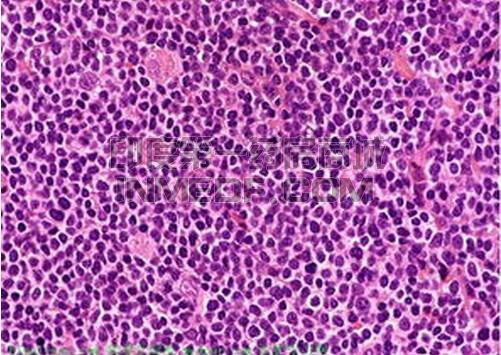
B细胞淋巴瘤

非霍奇金
淋巴瘤(NHL)根据其起源于B淋巴细胞(B细胞)还是T淋巴细胞(T细胞),通常分为B&T两种主要类型,B细胞
淋巴瘤有许多不同的亚型。
治疗药物
1、弥漫性大B细胞淋巴瘤(DLBCL)
弥漫性大B细胞淋巴瘤(Diffuse large B cell lymphoma,DLBCL)是非霍奇金淋巴瘤(NHL)最常见的1个亚型。
治疗弥漫性大B细胞淋巴瘤(DLBCL)很多药物,如下:
利妥昔单抗(Rituximab)
Kymriah(Tisagenlecleucel)
Yescarta(axicabtagene ciloleucel)益基利仑赛注射液
Monjuvi(
tafasitamab-cxix)
安适利(
维布妥昔单抗)Adcetris(Brentuximab vedotin)
Polivy(polatuzumab vedotin-piiq)维博妥珠单抗
Breyanzi(lisocabtagene maraleucel,liso-cel)
Zynlonta(loncastuximab tesirine-lpyl,Lonca)
倍诺达(瑞基奥仑赛注射液,relma-cel)
2、原发性纵隔大B细胞淋巴瘤(PMBL)
原发性纵隔大B细胞淋巴瘤(Primary mediastinal B-cell lymphoma,PMBL)其治疗类似于早期弥漫性大B细胞淋巴瘤。
3、滤泡性淋巴瘤(FL)
滤泡性淋巴瘤(Follicular lymphoma,FL)是化疗和放疗最有效的恶性
肿瘤之一。滤泡性淋巴瘤有很高的比例转化为弥漫性大B细胞淋巴瘤(DLBCL)。
4、小淋巴细胞淋巴瘤(SLL)
小淋巴细胞淋巴瘤(Small lymphocytic lymphoma,SLL)往往与慢性淋巴细胞
白血病(CLL)同时发生。
利妥昔单抗(Rituximab)
Arzerra(ofatumumab)奥法木单抗
Gazyva(Obinutuzumab)阿托珠单抗/奥比妥珠单抗
Campath(Alemtuzumab)坎帕斯(阿仑单抗注射液)
伊布替尼(Ibrutinib)
Brukinsa(zanubrutinib)泽布替尼
Copiktra(Duvelisib)
奥布替尼(Orelabrutinib)
5、套细胞淋巴瘤(MCL)
初次诊断时已广泛扩散的套细胞淋巴瘤(Mantle cell lymphoma,MCL),通常用化疗加利妥昔单抗治疗。
利妥昔单抗(Rituximab)
伊布替尼(Ibrutinib)
泽布替尼(Zanubrutinib)
奥布替尼(Orelabrutinib)
Tecartus(Brexucabtagene autoleucel)
6、巨球蛋白血症(WM)
巨球蛋白血症分为原发性和继发性,原发性巨球蛋白血症(Waldenstrom macroglobulinemia,WM)又称华氏巨球蛋白血症,或者是淋巴浆细胞性淋巴瘤(lymphoplasmacytic lymphoma,LPL)。
7、胃MALT淋巴瘤
胃MALT淋巴瘤是来源于胃粘膜固有层后形成的粘膜相关淋巴样组织(Mucosa-associatedlymphoid tissuee,MALT)内的反应性淋巴滤泡的套细胞区域(Mantle zone)B细胞发生的
肿瘤,属于惰性肿瘤。
抗生素与质子泵抑制剂
伊布替尼(Ibrutinib)
利妥昔单抗(Rituximab)
8、淋巴结边缘区B细胞淋巴瘤(MZBL)
边缘区B细胞淋巴瘤(marginalzoneB-celllymphoma,MZBL),属于惰性肿瘤。
利妥昔单抗(Rituximab)
Zevalin(ibritumomab tiuxetan)泽维宁(替伊莫单抗)
Ukoniq(umbralisib)
结内单核细胞样B细胞淋巴瘤(monocytoid B lymphocytes,MBLs)
9、脾边缘区B细胞淋巴瘤(SMZL)
脾边缘区淋巴瘤(Splenic marginal zone lymphoma,SMZL)属于边缘区B细胞淋巴瘤(MZBL)的一个亚型。
利妥昔单抗
Imbruvica(Ibrutinib)亿珂(伊布替尼)
百悦泽(泽布替尼)Brukinsa(Zanubrutinib)
毛细胞白血病(Hairy Cell Leukemia,HCL)是一种特殊类型的慢性淋巴细胞白血病(CLL),侵犯脾脏和淋巴结以及血液,该病发展缓慢,没有症状的患者通常不需要立即接受治疗,但需要每隔几个月接受检查是否有发展的迹象。
利妥昔单抗(Rituximab)
Lumoxiti(moxetumomab pasudotox)
11、伯基特淋巴瘤(Burkitt lymphoma)
1、Hyper-CVAD
1、Hyper-CVAD
1、Hyper-CVAD
12、原发性中枢神经系统淋巴瘤(PCNSL)
原发性中枢神经系统淋巴瘤(Primary central nervous system lymphoma,PCNSL)也称为中枢神经系统原发性弥漫性大B细胞淋巴瘤。
Velexbru(Tirabrutinib)替拉鲁替尼
13、眼淋巴瘤(PIOL)
原发性眼内淋巴瘤(Primary Intraocular lymphoma,PIOL)又名眼眶淋巴瘤,通常是中枢神经系统淋巴瘤(CNSL)/脑淋巴瘤的并发症。免疫功能正常患者中发生PCNSL和PIOL的发病机制尚不清楚。
甲氨蝶呤(Methotrexate)
利妥昔单抗(Rituximab)
多发性骨髓肿瘤细胞起源于骨髓中的浆细胞,浆细胞是B淋巴细胞发育到最终功能阶段的细胞,目前WHO将其归为B细胞淋巴瘤(BCL)的一种,称为浆细胞
骨髓瘤/浆细胞瘤。
Kyprolis(Carfilzomib)卡非佐米
Farydak(Panobinostat)帕比司他
沙利度胺(Thalidomide)
Pomalyst(Pomalidomide)
泊马度胺
Empliciti(Elotuzumab)埃罗妥珠单抗
Sarclisa(Isatuximab-irfc)
Blenrep(belantamab mafodotin-blmf)
Xpovio(selinexor)
Pepaxto(melphalan flufenamide)美法仑氟苯酰胺
Abecma(idecabtagenevicleucel)